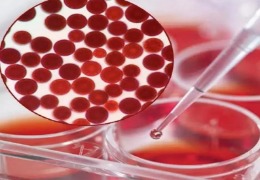
蝦青素的提取純化

蝦青素;蝦紅素;蝦廢棄物;提取;
時(shí)間:2022-11-27瀏覽:194
在蛋雞日糧中添加蝦青素,可以提高 DHA 雞蛋的儲(chǔ)存穩(wěn)定性,并發(fā)現(xiàn)了蝦青素對(duì) DHA 氧化的抑制作用及機(jī)制,為開(kāi)發(fā)高品質(zhì) DHA 強(qiáng)化雞蛋,以及 DHA、蝦青素雙重富集雞蛋提供了理論依據(jù)。有關(guān)團(tuán)隊(duì)還通過(guò)系列實(shí)驗(yàn)發(fā)現(xiàn)了蝦青素在雞蛋中的富集規(guī)律、存在形態(tài)、生物學(xué)功能及作用機(jī)制等,為蝦青素強(qiáng)…
時(shí)間:2022-11-26瀏覽:436
[摘要]簡(jiǎn)單概述了蝦青素的來(lái)源、組成和特性,并介紹了蝦青素在化妝品中的應(yīng)用。蝦青素是一種對(duì)人體具有一系列特殊保護(hù)功能且性能優(yōu)良的類胡蘿卜素,它用于化妝品,可起到護(hù)膚、免受紫外線(UVA,UVB)的損害等功能。本文展望了其在今后國(guó)內(nèi)日化市場(chǎng)上的發(fā)展前景,為蝦青素資源的充分開(kāi)發(fā)利用提供…
時(shí)間:2022-11-26瀏覽:432